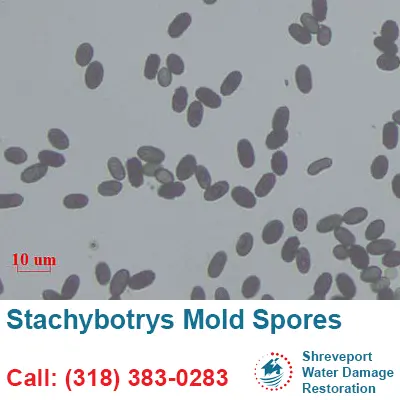
Stachybotrys Mold Spores

Mold Removal and Remediation
Mold Inspections, Testing, and Remediation in Shreveport, LA

Mold spores are pervasive and can be found almost anywhere. As long as the temperature and the amount of moisture in the air remain within typical ranges, you will not have a problem.
The mold spores remain in a state of dormancy. When the equilibrium is broken, however, as in the case of fire or water damage, the spores begin to develop fast.
If you think you have a mold problem, you should get in touch with an expert right away. Mold can have disastrous effects on your home and health if it isn't removed promptly.
What are the health risks associated with mold exposure?
Mold is a type of fungus that can grow both indoors and outdoors. Mold spores are tiny and can be found in the air, on surfaces, or in soil. When mold spores land on a wet or damp surface, they can start to grow. Mold exposure can cause a number of health problems, including allergic reactions, asthma, and other respiratory problems.
Symptoms Can Include
- Irritation of the lungs and throat
- Allergic Reactions
- Mycotoxicity
- Headaches
- Decline in lung health
- Asthma Set Off
- Recurring Cough or Cold Symptoms
- Itchy Feeling
Where will mold grow?
Mold growth is frequent in dark, damp, and poorly ventilated spaces, as well as in the aftermath of fire and water damage. Lack of proper ventilation can also lead to mold growth in a building. The mold will leave black stains on the walls, joints, or sealant margins. In many cases, a musty odor will also develop.
Common mold hotspots include: attics, basements, bathrooms, or kitchens. It can also be found in HVAC systems, on window sills, or in houseplants.
What are some common indoor mold species?
There are many different types of mold that can be found indoors, and the specific species will vary depending on the location and conditions within the home. Some common indoor mold species include Aspergillus, Cladosporium, Penicillium, Alternaria, and Stachybotrys.
What are the causes of mold growth in buildings?
Mold is a type of fungi that thrives in moist environments. Mold spores are found in the air and can enter a building through open doors, windows, or ventilation systems. Once mold spores land on a wet or damp surface, they begin to grow.
Mold growth is often the result of water leaks or flooding. If water leaks are not promptly cleaned up and the area is not properly dried, mold can begin to grow within 24 to 48 hours.
Our Approach To Mold Removal and Remediation
A unique strategy is required for each and every job. The outcomes of our inspection as well as the tests we ran on the quality of the air will determine the number of steps we take. The number of steps that we perform will be established based on the findings of our inspection as well as the analyses of the air quality. Nonetheless, the vast majority of our efforts are focused on thorough cleaning using commercial grade antibacterial agents.
How Can You Get Rid of Mold Yourself?
Baking soda, bleach, and specialized mold removers are just a few of the things you may get in the supermarket to get rid of mold on your own. However, there are several mold varieties, and not all DIY solutions work equally well against all of them. Our experts are pleased to lend a hand, as they have extensive experience in this field.
How do you prevent mold growth in your home?
There are a few things you can do to prevent mold:
- Keep your home clean and free of clutter. This will give mold fewer places to hide and make it easier to spot and clean up any mold that does appear.
- Fix any leaks in your home promptly. Mold loves damp, dark places, so leaking pipes or roofs provide the perfect environment for it to grow.
- Make sure your home has good ventilation.
Why You Should Call Us To Remove Mold
You can rest easy knowing that we will handle all of the necessary steps to remove mold.
As far as we know, no other company has taken the initiative to pioneer such solutions. Our comprehensive, around-the-clock customer support is designed to alleviate any concerns you may have. We will find the source of the leak, evaluate the damage, dry out the property, remove the mold, correct the problems, clean up the mess, and restore your home to its original condition.
We also coordinate with your insurance company to make sure you get the most money back possible for all of your legitimate costs.
